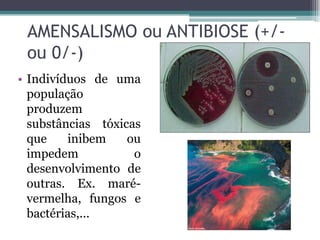
AMENSALISMO ou ANTIBIOSE (+/-
ou 0/-)
• Indivíduos de uma
população
produzem
substâncias tóxicas
que inibem ou
impedem o
desenvolvimento de
outras. Ex. maré-
vermelha, fungos e
bactérias,...

O documento discute conceitos fundamentais da ecologia, incluindo a interação entre seres vivos e seu ambiente, cadeias alimentares, fluxo de energia e matéria em ecossistemas, e pirâmides ecológicas. Explica que produtores fabricam energia orgânica por fotossíntese, heterótrofos consomem matéria orgânica, e decompositores reciclam nutrientes. A energia flui de produtores para diferentes níveis tróficos, diminuindo a cada transferência.